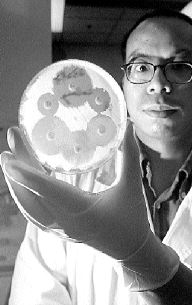
HONG_KONG_SUPERGERM

"Varios estudios recientes hallaron una relación entre el uso de teléfonos celulares y problemas menores de salud".
"Varios estudios recientes hallaron una relación entre el uso de teléfonos celulares y problemas menores de salud".
PANORAMA
Efectos nocivos de teléfonos celulares
La Oficina de Radioprotección de Salud de Canadá opina que los dolores de cabeza, la fatiga e incluso la depresión "pueden estar ligados al tiempo que pasa una persona usando su teléfono portátil", por lo que ha decidido llevar a cabo una investigación.
 "Varios estudios recientes hallaron una relación entre el uso de teléfonos celulares y problemas menores de salud".
"Varios estudios recientes hallaron una relación entre el uso de teléfonos celulares y problemas menores de salud".
Según investigadores escandinavos que analizaron a 17 mil personas, aquellos que usan teléfonos portátiles más de una hora por día corren más riesgo de sufrir dolores de cabeza que quienes los emplean menos de dos minutos por jornada.
La Oficina de Salud de Canadá no descarta que pueda haber un nexo entre el uso de esos teléfonos y enfermedades como el "cáncer de cerebro, linfomas o leucemia".
Los teléfonos celulares también podrían afectar negativamente a las personas bajo tratamiento médico.
La Oficina de Salud de Canadá asegura que "la energía RF (de las radiofrecuencias) absorbida por la cabeza humana cuando se utiliza un teléfono celular es inferior al límite máximo admitido específicamente en el código de seguridad".
Recomienda a los usuarios de teléfonos móviles "que duden de la inocuidad de esos aparatos" y "limiten cualquier peligro potencial reduciendo al mínimo su uso".
Las autoridades decidieron finalmente emprender un estudio a profundidad del problema, que podría durar varios años. (Afp)
n TIBURON ANCESTRAL

Una porción de restos fosilizados de un tiburón, estudiada en el Instituto de Fósiles de la Academia de Ciencias en Ulan Bator, fue encontrada en una villa al este de Mongolia. Se calcula que el fósil tiene entre 120 y 130 millones de años, y es el primer descubrimiento de ese tipo en dicha nación asiática n Foto: Ap
n DESCUBRIMIENTO VULCANOLOGICO

Los científicos que trabajan en la Isla Monserrat, en el Caribe, explicaron que la ceniza de las erupciones del volcán son más peligrosas de lo que habían creído. Sin embargo, comentaron que también han encontrado una mejor manera de predecir las explosiones. Dos estudios diferentes del coloso proporcionaron nueva información útil para reducir los riesgos de las personas que viven alrededor de volcanes activos similares en el mundo n Foto: Reuters
El cultivo de un estafilococo áureo, estudiado en un hospital médico de Hong Kong, ha probado resistencia a uno de los más potentes antibióticos disponibles contra la infección producida por esa bacteria n Foto: Ap

La tripulación que partió en un cohete ruso para acoplarse con la estación espacial Mir, podría ser la última de los más de 100 mujeres y hombres que han vivido y trabajado en ella desde que fue lanzada. El trío esta formado por un astronauta ruso y dos franceses n Foto: Ap